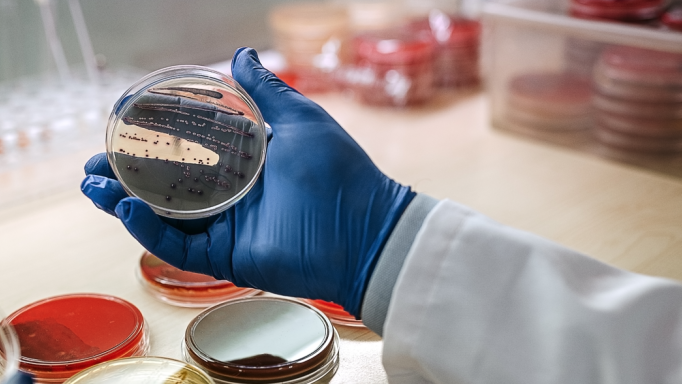

Alle Infos für Unternehmen auf einen Blick.
Hochwertige Lebensmittel bestehen aus hochwertigen Inhaltsstoffen. Wir bestimmen und verbessern Herkunft, Nährwert und funktionelle Eigenschaften von Rohstoffen und Zutaten. Aus Nebenprodukten entwickeln wir neue Produkte oder analysieren, extrahieren und stabilisieren wertvolle Substanzen. So verbessern wir die Nachhaltigkeit der Lebensmittelkette. Unser Anspruch: Kreislaufwirtschaft als erfolgreiches und zukunftsfähiges Business Model.
Wir erforschen, wie Roh- und Inhaltsstoffe schonend konserviert und wirksam verarbeitet werden. Uns interessieren Prozesse, die organoleptische und gesundheitsfördernde Eigenschaften von Lebensmitteln aktivieren. Dabei beschäftigen wir uns auch mit dem Zusammenhang zwischen Ernährung, Mikrobiom und Gesundheit. Im Fokus stehen im NOI die Fermentationsprozesse. Das uralte Verfahren der Konservierung führt die Lebensmittelindustrie in die Zukunft. Über Geschmack, Konsistenz und Nährstoffgehalt.
Phone
E-Mail-Adresse
In der Molekularbiologie sind wir zu Hause. Wir denken Gesundheit ganzheitlich und entwickeln auf Basis der biomedizinischen Forschung Lösungen im Bereich Precision Health. Durch unsere Kooperationen haben wir die Möglichkeit, biomedizinische Erkenntnisse in neue Therapien und Technologien zum Wohle der Bevölkerung umzusetzen. Wir treiben Entwicklungen voran und verbinden biomedizinische Forschung mit Lebensmittelinnovation. Unter dem Motto „from disease care to health care“ ebnen Interventionsstudien, bioinformatische Methoden oder Zellmodelle den Weg für innovative Gesundheitslösungen.
Phone
E-Mail-Adresse